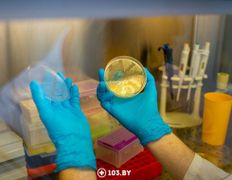
null Республиканский научно-практический центр детской онкологии, гематологии и иммунологии, Лаборатория генетических биотехнологий - фото 3

Обработка файлов cookie
Наш сайт использует файлы cookie для обеспечения удобства пользователей сайта, его улучшения, сбора статистики и предоставления персонализированных рекомендаций.
Вы можете настроить параметры использования файлов cookie или изменить свое согласие в более позднее время. Для получения дополнительной информации о целях, сроках и порядке использования файлов cookie вы можете ознакомиться с нашей Политикой обработки файлов cookie
Вы можете настроить параметры использования файлов cookie или изменить свое согласие в более позднее время. Для получения дополнительной информации о целях, сроках и порядке использования файлов cookie вы можете ознакомиться с нашей Политикой обработки файлов cookie
Персональные настройки Cookie